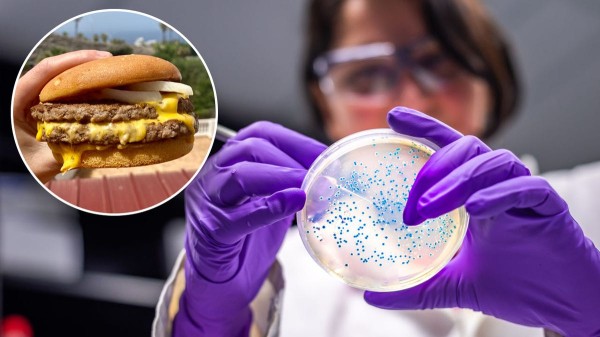
E. coli outbreak linked to McDonald’s burgers: How to spot the symptoms E. coli outbreak linked to McDonald’s burgers: How to spot the symptoms

E. coli outbreak linked to McDonald’s burgers: How to spot the symptoms

Join Fox News for access to this content Plus special access to select articles and other premium content with your account – free of charge. By entering your email and pushing continue, you are agreeing to Fox News’ Terms of Use and Privacy Policy, which includes our Notice of Financial Incentive. Please enter a valid email address. By entering your email and pushing continue, you are agreeing to Fox News’ Terms of Use and Privacy Policy, which includes our Notice of Financial Incentive. Having trouble? Click here.
A widespread E. coli outbreak has been linked to a McDonald’s product, according to the U.S. Centers for Disease Control and Prevention (CDC).
A total of 49 people across 10 states have reported infections after eating the Quarter Pounder hamburger from the fast-food chain, the agency stated in a food safety alert released on Tuesday.
Ten people were hospitalized, and one death has been reported.
A majority of the infections were reported in Colorado and Nebraska.
MCDONALD’S LINKED TO E. COLI OUTBREAK, CDC SAYS
McDonald’s is working with several health agencies — including the CDC, Food and Drug Administration (FDA), U.S. Department of Agriculture (USDA) and Food Safety and Inspection Service (FSIS) — to investigate which ingredient in the Quarter Pounders is leading to the illness, the CDC noted.
In the meantime, restaurant locations in some states have stopped using quarter-pound beef patties and slivered onions until the ingredient has been identified.
What is E. coli?
E. coli — officially known as Escherichia coli — is a type of bacteria found in the environment, foods and intestines of people and animals, according to the CDC.
Harry Kopolovich, MD, chairman of emergency medicine at Hackensack Meridian Jersey Shore University Medical Center, noted that E. Coli is a commonly occurring bacteria.
FAUCI SAYS WEST NILE VIRUS WAS A ‘HARROWING’ EXPERIENCE: ‘AFRAID I WOULD NEVER RECOVER’
“E. Coli is a natural part of our collective GI system,” he told Fox News Digital.
“Most strains are harmless and exist in our gut as part of the normal flora that supports good digestive health.”

Certain subtypes of the strain, specifically 0157:H7, can cause serious disease and death in a subset of individuals, the doctor cautioned.
“Given that E. coli is so present in the environment, it can easily spread from individual to individual by poor hygienic processes,” he added.
“Given that E. coli is so present in the environment, it can easily spread from individual to individual by poor hygienic processes.”
Dr. Marc Siegel, clinical professor of medicine at NYU Langone Medical Center and a Fox News medical contributor, previously told Fox News Digital that E. coli is an intestinal bacteria that may propagate in cows and chickens used for meat, “especially when they are raised in squalor or together.”

“Since poultry and meat cows are often fed antibiotics to help them grow and to ward off infections, this helps to breed resistant strains, which emerge amid antibiotic overuse,” Siegel added.
The outbreak likely stemmed from meat not being cooked enough, the doctor said, or it could have spread through uncooked vegetables, such as the onions on the burgers.
“Food handlers can also spread it,” Siegel added.
SUPERBUGS DUE TO ANTIBIOTIC RESISTANCE COULD KILL 39 MILLION PEOPLE BY 2050, LARGE STUDY FINDS
The best way to avoid infection is to use “good and common sense precautions,” Kopolovich said.
These include handwashing and thoroughly disinfecting food preparation surfaces, as well as cooking food to the appropriate temperature to avoid foodborne illness.
Symptoms and treatment
Symptoms of E. coli illness include — but are not limited to — severe stomach cramps, diarrhea (often bloody), vomiting, respiratory illness, urinary tract infections, fever and pneumonia, according to the CDC.

“Most of the time, it causes cramping and diarrhea and even bloody stools, but you typically recover in about a week,” Siegel said.
After exposure, the infection has a “dormant or incubation period” of roughly three days, Kopolovich noted, but it can be as long as 10 days following consumption.
CLICK HERE TO GET THE FOX NEWS APP
“Most people tend to recover without any treatment after approximately five to seven days,” he said.
Although rare, some people with E. coli can develop hemolytic uremic syndrome (HUS), which can lead to kidney failure or other life-threatening complications, per the CDC.

“Anywhere from 15% to 20% of children infected with STEC will go on to develop a complication of HUS, which is characterized by an abrupt decrease in hemoglobin, platelet counts and an acute kidney injury,” Kopolovich told Fox News Digital.
Symptoms of HUS include extreme fatigue, decreased urination and loss of color in the face and lower eyelids.
CLICK HERE TO SIGN UP FOR OUR HEALTH NEWSLETTER
The CDC recommends seeing a health care provider for “diarrhea that lasts for more than three days or diarrhea that is accompanied by a fever higher than 102˚F, bloody diarrhea, or so much vomiting that you cannot keep liquids down and you pass very little urine.”
People should also seek medical attention for abdominal pain that does not improve with Tylenol (acetaminophen), according to Kopolovich.

Patients who take medications or have a preexisting medical condition — such as an autoimmune disease, heart failure or kidney disease — could be at a higher risk for serious complications, the doctor added.
“You can’t really treat with antibiotics because when the bacteria die, more of the toxin is released,” Siegel said. “So you have to treat with supportive care and hydration.”
For more Health articles, visit www.foxnews.com/health
Fox News Digital reached out to McDonald’s for comment.
McDonald’s North America chief supply chain officer Cesar Piña said in an internal statement that the company is “taking swift and decisive action” to address the outbreak, and reported that “the initial findings from the investigation indicate that a subset of illnesses may be linked to slivered onions used in the Quarter Pounder and sourced by a single supplier that serves three distribution centers.”
Fox News Digital’s Breck Dumas contributed reporting.
Melissa Rudy is senior health editor and a member of the lifestyle team at Fox News Digital. Story tips can be sent to melissa.rudy@fox.com.
